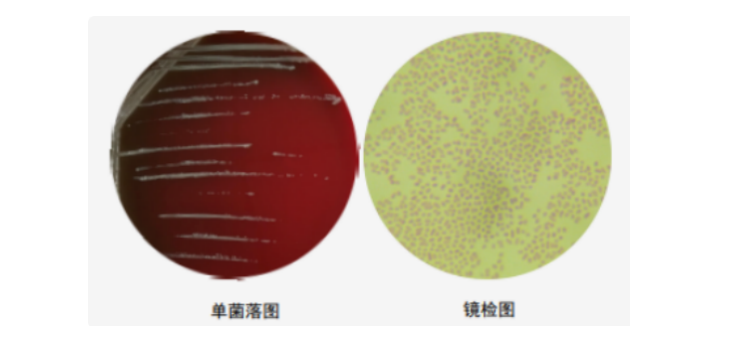

今日门诊又遇到了一名因咳嗽就诊的1月余的小婴儿,宝妈诉孩子咳嗽四五天了,也不频繁,不咳嗽的时候跟正常孩子一样,一旦咳嗽起来就比较剧烈,咳嗽后有吐奶。
接诊医生问了宝妈两个问题:孩子咳嗽时是否有像鸡鸣一样的尾音?宝妈说没有;家里是否有咳嗽的病人?妈妈说孩子哥哥已经咳嗽半个多月。经过问诊和查体,新生儿科医生为孩子进行了咽拭子检查,并送检了“百日咳鲍特菌”核酸检测,结果呈阳性。
百日咳,大家对这个名字应该不陌生,因为我们都会接种百白破疫苗。很多人以为随着疫苗的普及,百日咳已经消失了,但实际并非如此。虽然疫苗接种使百日咳发病率大幅下降,病死率显著降低,但自20世纪80年代以来,部分疫苗高覆盖率的发达国家出现“百日咳再现”的现象,我国2011年后也出现这一公共卫生问题。据国家疾病预防控制局数据显示,我国2024年1-3月份累计报告病例数已超过去6年的总和。而且它的发病年龄并非仅见于小婴儿,青少年和成人不典型病例亦明显增多。百日咳属于乙类传染病,重症感染可导致肺炎、肺动脉高压、颅内出血、惊厥、抽搐等,甚至危及生命,因此,早发现、早诊断、早隔离、早治疗尤为重要。接下来顺义妇儿医院新生儿科詹实娜副主任医师就来介绍一下百日咳这一死灰复燃的传染病。
百日咳(osleoartbrilis,OA)是由百日咳鲍特菌引起的具有高度传染性的急性呼吸道传染病。
一、百日咳的临床表现:
阵发性痉挛性咳嗽、伴有“鸡鸣”样吸气性哮吼声和咳嗽后呕吐是百日咳的典型表现。病程可分为卡他期、痉咳期和恢复期。
卡他期:表现为轻咳等上呼吸道感染症状,持续时间一般1-2周。
痉咳期:阵发性痉挛性咳嗽,常有似“鸡鸣”样的尾音,发作的频率及严重程度逐渐增加,可自发出现,也可由外界刺激诱发。新生儿可出现咳嗽后呕吐、发绀和呼吸困难等症,持续2-8周。
恢复期:症状逐渐消退,但合并呼吸道感染后可能再次出现阵发性咳嗽或原有咳嗽加重。
新生儿百日咳临床表现存在个体差异且临床表现不典型,病程分期不明确,卡他期时间短或无,表现为咳嗽轻微、无发热或低热、无鼻塞等;痉咳期可合并呼吸暂停、癫痫发作、呼吸窘迫、肺炎、肺动脉高压、低血压/休克、肾衰竭等。恢复期易合并反复呼吸道感染,病程迁延。
二、百日咳的诊断
除典型临床表现外,通过化验检查协助明确。特异性实验室检查包括核酸扩增法检测百日咳鲍特菌核酸、百日咳细菌培养、百日咳血清抗体滴度检测。而鉴于核酸扩增法灵敏度高,检测快速,临床中得到普及应用。而标本采集优先推荐采集鼻咽拭子,其次是鼻咽吸取液。其他常规检查包括外周血常规、C反应蛋白、降钙素原、胸部X线、心脏超声等,以鉴别其他病原体感染及评估病情严重程度。
典型的百日咳进入卡他期后,血白细胞计数及淋巴细胞比例开始升高,至痉咳期达高峰:WBC计数可达(20-50)x109/L,少数达70x109/L以上;淋巴细胞比例可升高至60%-80%。当合并细菌感染时外周血中性粒细胞比例可增高。白细胞及淋巴细胞计数水平升高与病情严重程度相关。
三、百日咳预防
疫苗接种是预防百日咳最好的方法。最新指南建议2月龄婴儿开始接种含百日咳成分的疫苗。因4—6岁后疫苗抗体滴度已很低,因此,推荐学龄前儿童加强接种1剂次。而对于2月龄以下的婴儿尚未接种疫苗,近年数据亦显示该群体感染呈上升趋势,该如何保护呢?欧洲已实施怀孕后家庭成员均补种百日咳疫苗,一方面提高母体百日咳抗体,以提高新生儿及小婴儿抗体水平增强免疫力,另一方面家庭成员接种以最大限度减少因家庭成员感染导致小婴儿感染率。目前,我国尚未普及这种预防接种方式。但随着近年对百日咳流行病学等的研究,小婴幼儿发病率明显上升,我国专家亦提出了孕期补种疫苗的必要性。
对于特殊人群,如早产儿,建议早产儿在出院时或出院后,临床评估稳定状态下,按实际月龄接种首剂含百日咳成分的疫苗;有神经系统疾病的患儿(如脑瘫、发育迟缓、有热性惊厥史、控制良好的癫痫儿童)可以常规接种含百日咳成分的疫苗;对进展性或病情不稳定的神经系统疾病患儿,建议推迟接种,待病情稳定后再恢复接种;如既往接种含百日咳成分的疫苗后48h内发生低张力、低反应发作或者3d内发生惊厥、有惊厥家族史仍可接种;如既往接种7d内出现脑病症状,应查找病因,病因不明者不推荐接种,明确排除与疫苗接种有关联的,病情稳定后可以继续接种。
四、百日咳的治疗:
首选大环内酯类药物:鉴于阿奇霉素用药时间短,不良反应更少,因此,阿奇霉素为首选用药。而新生儿百日咳感染,首选的治疗用药为静脉输注红霉素或口服阿奇霉素。
而对于大环内酯类耐药者:2月龄以上儿童和成人首选复方磺胺甲噁唑(即复方新诺明);2月龄及以下婴儿建议用头孢哌酮舒巴坦或哌拉西林他唑巴坦;成人可选左氧氟沙星替代。
对于重症百日咳患儿:高白细胞血症重症百日咳患儿推荐白细胞去除术治疗;百日咳痉挛性咳嗽期接受全身激素治疗。
治疗时机:越早治疗越好。在百日咳患者发病2周内尤其是7d内接受有效抗菌药物治疗可以减轻咳嗽症状,缩短咳嗽时间,明显减少继发传播,减少肺炎并发症,并有可能降低3月龄以下小婴儿百日咳病例的病死率。
百日咳病例,绝大多数属于社区获得性感染,其传播主要通过已感染或带菌者实现水平传播,因此,我们要养成洗手和到人员聚集的地方戴口罩的习惯。同时该病早期与普通上呼吸道感染难以鉴别,容易误诊,但百日咳有其自身的特点。因此,通过本篇科普,家长可观察宝宝咳嗽特点,以协助医生给予更好的针对性检查和治疗,以达到早诊断、早治疗的目的。
文/詹实娜 (顺义区妇幼保健院新生儿科)
编辑/周超